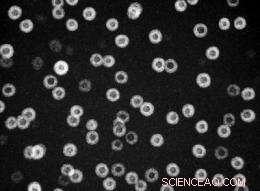
Unveiling the Nanoscale Key to Enhancing Alloy Strength

When aluminum is alloyed with the right proportions of scandium and lithium through a simple series of heat treatments, nanoparticle inclusions form in the aluminum matrix (dark background) whose cores, made of aluminum, scandium, and lithium (dark circles), vary in diameter and whose shells, made of aluminum and lithium (bright rings), vary in thickness. But their overall diameters are remarkably uniform. Credit: Lawrence Berkeley National Laboratory
Long before they knew they were doing it – as long ago as the Wright Brother's first airplane engine – metallurgists were incorporating nanoparticles in aluminum to make a strong, hard, heat-resistant alloy. The process is called solid-state precipitation, in which, after the melt has been quickly cooled, atoms of alloying metals migrate through a solid matrix and gather themselves in dispersed particles measured in billionths of a meter, only a few-score atoms wide.
Key to the strength of these precipitation-hardened alloys is the size, shape, and uniformity of the nanoparticles and how stable they are when heated. One alloy with a highly successful combination of properties is a particular formulation of aluminum, scandium, and lithium, whose precipitates are all nearly the same size. It was first made at the U.S. Department of Energy's Lawrence Berkeley National Laboratory (Berkeley Lab) in 2006 by a team led by Velimir Radmilović and Ulrich Dahmen of the Materials Sciences Division.
These scientists and their colleagues have now combined atomic-scale observations with the powerful TEAM microscope at Berkeley Lab's National Center for Electron Microscopy (NCEM) with atom-probe tomography and other experimental techniques, and with theoretical calculations, to reveal how nanoparticles consisting of cores rich in scandium and surrounded by lithium-rich shells can disperse in remarkably uniform sizes throughout a pure aluminum matrix.
"With the TEAM microscope we were able to study the core-shell structure of these nanoprecipitates and how they form spheres that are nearly the same in diameter," says Dahmen, the director of NCEM and an author of the Nature Materials paper describing the new studies. "What's more, these particles don't change size over time, as most precipitates do. Typically, small particles get smaller and large particles get larger, a process called ripening or coarsening, which eventually weakens the alloys. But these uniform core-shell nanoprecipitates resist change."
Evolution of an alloy
In the aluminum-scandium-lithium system the researchers found that, after the initial melt, a simple two-step heating process creates first the scandium-rich cores and then the lithium-rich shells of the spherical particles. The spheres self-limit their growth to achieve the same outer dimensions, yielding a lightweight, potentially heat- and corrosion-resistant, superstrong alloy.
"Scandium is the most potent strengthener for aluminum," says NCEM's Radmilović, who is also a professor of metallurgy at the University of Belgrade, Serbia, and an author of the Nature Materials paper. "Adding less than one percent scandium can make a dramatic difference in mechanical strength, fracture resistance, corrosion resistance – all kinds of properties." Because scandium diffuses very slowly through the solid aluminum matrix, the solid mix must be heated to a high temperature (short of melting) before scandium will precipitate.
Lithium is the lightest of all metals (only hydrogen and helium are lighter) and brings not only lightness to an aluminum alloy but, potentially, strength as well. Lithium diffuses much more rapidly than scandium, at much lower temperature.
"The problem is that, by itself, lithium may not live up to its promise," says Dahmen, a long-time collaborator with Radmilović. "The trick is to convince the lithium to take on a useful crystalline structure, namely L12."
The L12 unit cell resembles a face-centered cubic cell, among the simplest and most symmetric of crystal structures. Atoms occupy each corner of an imaginary cube and are centered in the cube's six faces; in the L12 structure, the kinds of atoms at the corners may differ from those at the centers of the faces. For alloy inclusions it's one of the strongest and stablest of structures because, as Dahmen explains, "once atoms are in place in L12, it's difficult for them to move."
Dahmen credits Radmilović with the "intuition" to alloy both scandium and lithium with aluminum, heating and cooling the material in a specific series of steps. That intuition was based on Radmilović's long experience with the separate properties of aluminum-lithium and aluminum-scandium alloys and a deep understanding of how they were likely to interact. He drew up a recipe for the proportions of ingredients in the initial melt and how to cool and rewarm them.
The key to the process was to use lithium as a kind of catalyst to force a "burst of nucleation" in the scandium. After the three metals are mixed, melted, and quickly cooled or quenched, lithium serves to lower the heating needed to coax scandium to form dense core structures – although the solid mix must still be heated to 450 degrees Celsius (842 Fahrenheit) for 18 hours to form these cores, made of aluminum, lithium, and scandium. The cores average a little over nine nanometers in diameter but are not uniform in size.
Next the alloy is heated again, this time to 190˚ Celsius (374˚ F) for four hours. At the lower temperature the scandium is immobile; the freely-moving lithium forms a shell around the scandium-rich cores, much as water in a cloud crystallizes around a speck of dust to make a snowflake. The shells average about 10.5 nanometers in thickness, but their thickness is not uniform.
What's remarkable, though, is that when a core is thicker than the average, the shell is thinner than the average, and vice versa: the smaller the core, the faster the shell grows. Core size and shell size are "anticorrelated" and the result is "size focused." Whole spheres still vary somewhat, but the differences are much less than among the cores alone or the shells alone.

The L12 structure is shown at lower left, with aluminum atoms in gray and scandium or lithium atoms reddish green. In images of a core-shell nanoparticle made by NCEM’s TEAM microscope, each dot shows the top of a column of atoms; the kinds of atoms in each column can be calculated from the brightness and contrast of the dots. The aluminum matrix has a face-centered cubic structure in which all the atoms are aluminum, while in the L12 structure the face-centered positions are also aluminum. But in the core of the nanoparticle (upper right), the columns at the corners of the L12 unit cell are a mix of aluminum, lithium, and scandium atoms, while in the surrounding shell (lower right), the corner columns are a mix of aluminum and lithium. Credit: Lawrence Berkeley National Laboratory
The structure of the cores and shells embedded in aluminum seems equally remarkable. Pure aluminum itself has a face-centered-cubic structure, and this structure is seamlessly repeated by the L12 structure of both the cores and the shells, perfectly joined with no dislocations at the interfaces between core, shell, and matrix.
Dahmen says, "It's the scandium-rich cores that convince the lithium to take on the useful L12 structure."
Joining experiment with theory
Using the TEAM microscope and a special imaging technique to look down at the tops of the regular rows of columns of atoms, the L12 structure reveals itself in groups of interlocking squares, with four columns of atoms at the corners and five columns of atoms at the lined-up centers of the faces.
In pure aluminum, all the dots are the same brightness. In the shells and cores, however, the corner columns and the face-centered columns differ in contrast – the face-centered columns are pure aluminum but the corner columns are mixed. By supplementing the high-resolution TEAM images with data from other experimental techniques it was possible to use brightness and contrast to calculate the kinds of atoms in each column.
By employing first-principles calculations, team members Colin Ophus and Mark Asta were able to model the effect of lithium on the solid-state precipitation of scandium, stimulating a sudden burst of nucleation, and also to understand why, because of the thermodynamic properties of the two metals interacting with aluminum and with each other, the precipitates are so uniform and stable.
Radmilović says, "Colin and Mark showed that lithium and scandium like each other. They also showed that by using the aluminum columns as a standard, we can calculate the intensity of the scandium and lithium by the brightness of the spot." In the shells, the corner columns contain aluminum and about 10 percent lithium. In the cores, the corner columns contain all three metals.
Dahmen says, "In recent years there has been a rapid increase in the use of 'integrative microscopy' - using a variety of techniques such as high-angular annular dark-field imaging, high-resolution phase contrast, and energy-filtered imaging and spectroscopy to attack a single problem. The TEAM microscope, which is corrected for both chromatic and spherical aberration, is unique in its ability to do all these techniques with high resolution. Understanding why nanoinclusions in aluminum-scandium-lithium are uniform is one of the best examples for the need to use integrative microscopy."
As good an alloy as aluminum-scandium-lithium is, its use may be limited by the cost of rare scandium, presently ten times the price of gold. By understanding how the alloy achieves its remarkable characteristics, the researchers fully expect that other systems with core-shell precipitates can be controlled by the same mechanisms, leading to new kinds of alloys with a range of desirable properties.